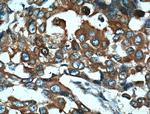
TARS Antibody in Immunohistochemistry (Paraffin) (IHC (P))

Search
Proteintech
TARS Polyclonal Antibody
{{$productOrderCtrl.translations['antibody.pdp.commerceCard.promotion.promotions']}}
{{$productOrderCtrl.translations['antibody.pdp.commerceCard.promotion.viewpromo']}}
{{$productOrderCtrl.translations['antibody.pdp.commerceCard.promotion.promocode']}}: {{promo.promoCode}} {{promo.promoTitle}} {{promo.promoDescription}}. {{$productOrderCtrl.translations['antibody.pdp.commerceCard.promotion.learnmore']}}
产品信息
14773-1-AP
种属反应
宿主/亚型
分类
类型
抗原
偶联物
形式
浓度
规格
纯化类型
保存液
内含物
保存条件
运输条件
产品详细信息
Immunogen sequence: ENMFSFEVE KELFALKPMN CPGHCLMFDH RPRSWRELPL RLADFGVLHR NELSGALTGL TRVRRFQQDD AHIFCAMEQI EDEIKGCLDF LRTVYSVFGF SFKLNLSTRP EKFLGDIEVW DQAEKQLENS LNEFGEKWEL NSGDGAFYGP KIDIQIKDAI GRYHQCATIQ LDFQLPIRFN LTYVSHDGDD KKRPVIVHRA ILGSVERMIA ILTENYGGKW PFWLSPRQVM VVPVGPTCDE YAQKVRQQFH DAKFMADIDL DPGCTLNKKI RNAQLAQYNF ILVVGEKEKI SGTVNIRTRD NKVHGERTIS ETIERLQQLK EFRSKQAEEE F (394-723 aa encoded by BC000517)
靶标信息
Aminoacyl-tRNA synthetases catalyze the aminoacylation of tRNA by their cognate amino acid. Because of their central role in linking amino acids with nucleotide triplets contained in tRNAs, aminoacyl-tRNA synthetases are thought to be among the first proteins that appeared in evolution. Threonyl-tRNA synthetase belongs to the class-II aminoacyl-tRNA synthetase family.
仅用于科研。不用于诊断过程。未经明确授权不得转售。
生物信息学
蛋白别名: MGC9344; threonine tRNA ligase 1, cytoplasmic; Threonine--tRNA ligase 1, cytoplasmic; threonine--tRNA ligase, cytoplasmic; Threonyl-tRNA synthetase; Threonyl-tRNA synthetase 1; threonyl-tRNA synthetase, cytoplasmic; ThrRS; unnamed protein product
基因别名: TARS; TARS1; ThrRS; TTD7
UniProt ID: (Human) P26639
Entrez Gene ID: (Human) 6897